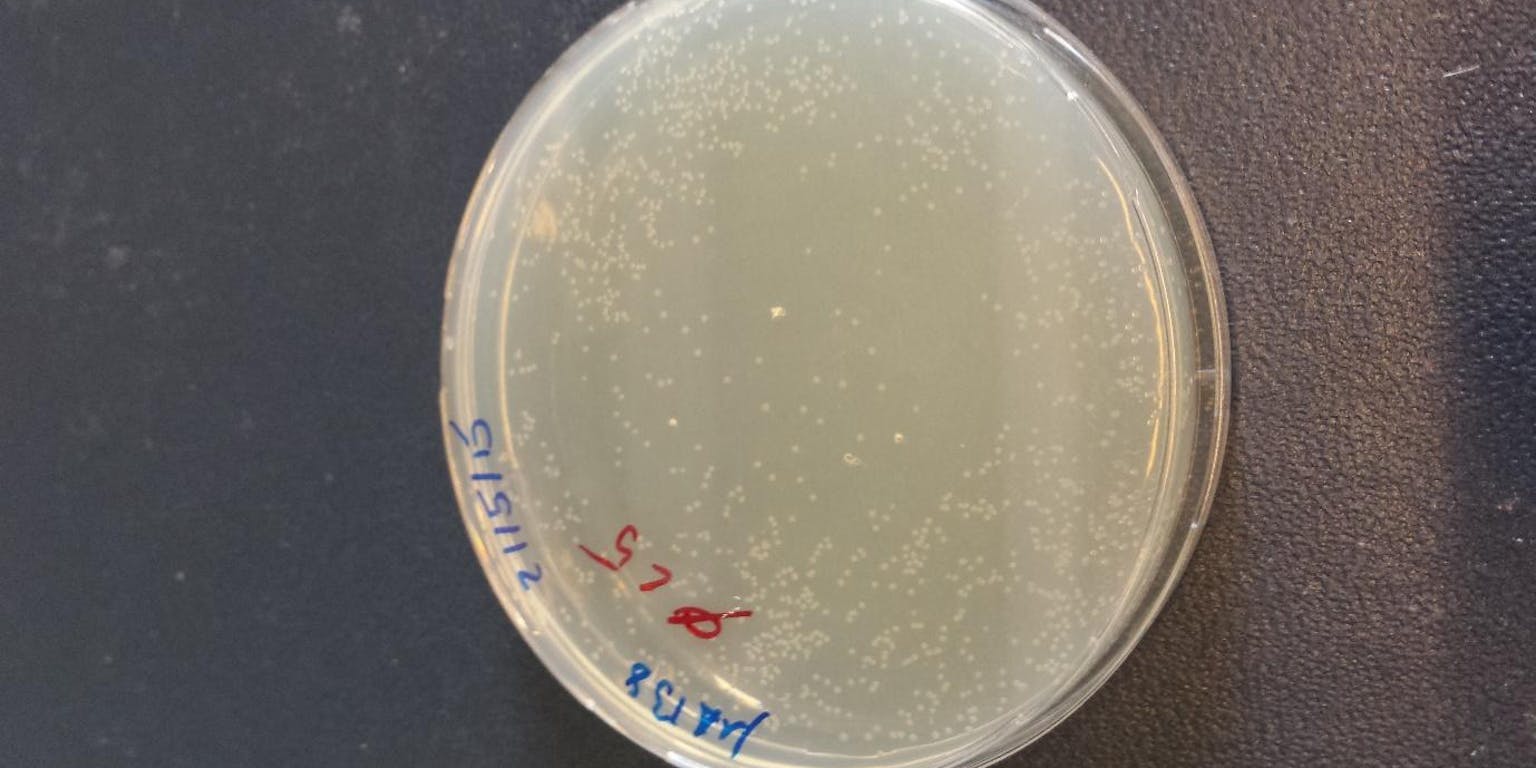

Hoe kopieer je DNA?
In ons lab gebruiken we DNA-stukjes om cellen extra eigenschappen te geven. We geven bijvoorbeeld een fluorescerend kleurtje aan een interessant gen zodat we het goed kunnen volgen onder een microscoop. Er zijn veel manieren om dit soort stukjes DNA te maken. Uiteindelijk komt het door ons gefabriceerde gen te zitten in een kleine DNA-ring. Deze ring van DNA noemen we een plasmide. Die ring zorgt ervoor dat de cel onze nieuwe gen om kan zetten in een functionerend eiwit. (Als je even wil nalezen hoe het ook alweer zat met DNA, genen en eiwitten, kijk dan hier).
Kopieermachine voor moleculen
Dus we hebben één plasmide gemaakt, maar dat is slechts genoeg voor één cel en we willen heel veel DNA kopiëren. Elke cel waarin je het eiwit wil kunnen zien, moet ten minste een kopie van zo’n plasmide krijgen, dus je hebt fors wat plasmiden nodig! Op zoek naar een soort kopieermachine voor moleculen. En de beste ‘machines’ daarvoor zijn bacteriën. Die bevatten van nature al plasmiden en ze gebruiken ze bijvoorbeeld om DNA-informatie uit te wisselen met buren. Maar wij bemoeien ons daar verder niet mee en maken alleen gebruik van de kopieerservice. Bacteriën hebben twee voordelen: ze kunnen snel plasmiden kopiëren, en ze delen ook nog heel snel.
Bacteriële vakantiepret
Hoe krijg je dan je plasmide in een bacterie? Daar zijn verschillende manieren voor bedacht. Wij gebruiken heat-shocks: Je mengt kleine hoeveelheden DNA en bacteriën in een buisje en verwarmt dit mengsel enkele seconden. Door de plotselinge warmte gaan kleine poriën in het membraan van de bacteriën open en kan de kleine DNA-ring makkelijk naar binnen. Daarna geven we onze bacteriën veel medium om in te groeien en mogen ze naar een lekker warme incubator – dat is voor hun en soort van all-inclusive vakantie. De volgende ochtend hebt je dan een hele beker vol bacteriën allemaal volgepropt met plasmiden.
Dan is de bacteriële vakantiepret helaas klaar. En het is geen dankbare taak voor de bacteriën, want om aan die plasmiden te komen moeten we ze wel kapotmaken. Vervolgens nog even het DNA opzuiveren en in water oplossen – en klaar zijn ontelbaar veel kopieën van de originele DNA-ring.
We beginnen met een kleine kolonie bacteriën, zodat we zeker weten dat alle bacteriën identiek zijn.
Max Adrian voor NEMO Kennislink
Dan laten we de bacteriën in een klein buisje groeien. We nemen genoeg buisjes om een paar tests te doen.
Max Adrian voor NEMO Kennislink
Als alles goed is, stoppen we een kleine druppel met bacteriën uit het buisje in een grotere fles. De volgende ochtend zit die fles vol bacteriën en kunnen we het DNA opzuiveren. Genoeg voor meer dan honderd proeven!
Max Adrian voor NEMO Kennislink